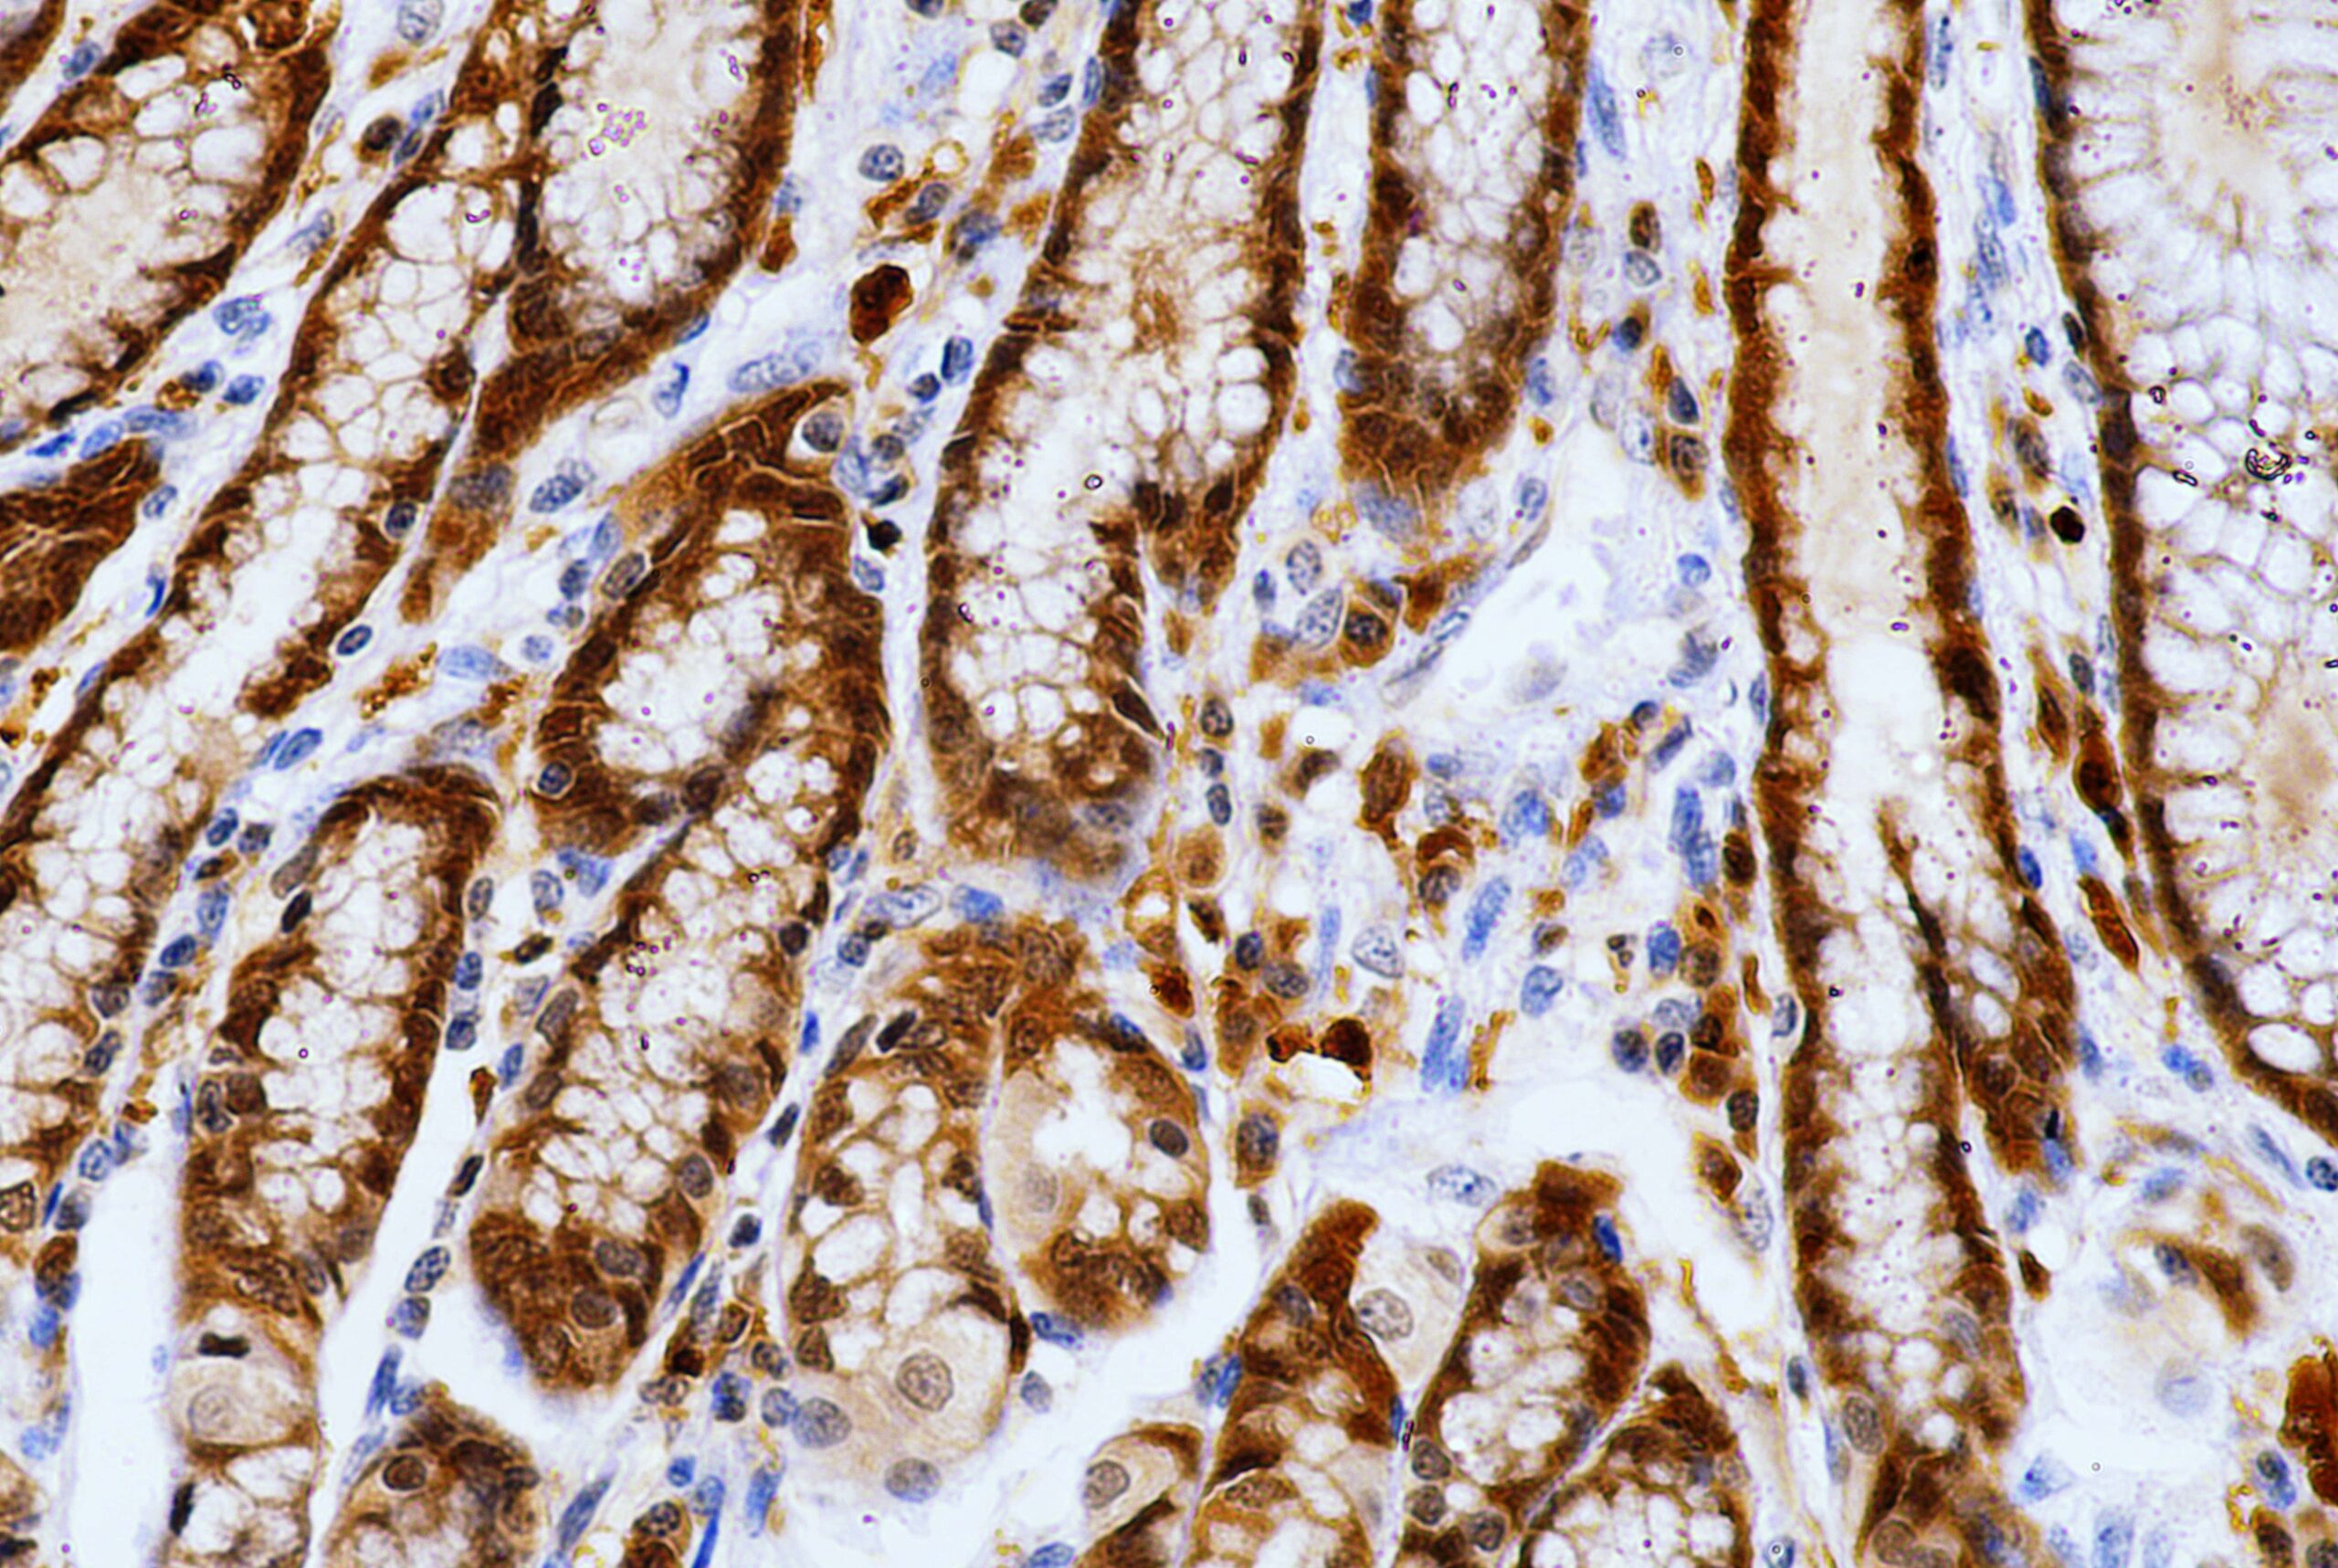
AMB42

Anti-Caspase-3, Clone 31A1067
Caspase-3, also known as apopain, SCA-1, Yama and CPP32, is an aspartate-specific cysteine protease that belongs to the interleukin-1 ?-converting enzyme subfamily of caspases.Caspase-3 is synthesized as an inactive proenzyme (32 kDa) that
is processed in cells undergoing apoptosis by self-proteolysis and/or further cleaved by another upstream protease generating two subunits of 17 kDa and 12 kDa. These sub units activates other caspases, as well as relevant targets in the cells such as PARP and DFF. The human caspase-3 gene encodes a cytoplasmic protein that is highly expressed in epithelial cells of skin, renal proximal tubules and collecting ducts, lung, spleen, heart, liver and cells of the immune system.
| Intended Use | IVD |
|---|---|
| Antibody Type | Monoclonal |
| Source | Mouse |
| Clone | 31A1067 |
| Tissue Type | Liver tissue |
| Pack | 0.5 mL – Manual – Concentrate, 1 mL – Manual – Concentrate, 6 mL – Manual – RTU, 50 Tests – Automation – Xmatrx, 100 Tests – Automation – i6000, 160 Tests – Automation – Xmatrx, 5 slides – Xmatrx, 5 slides – Manual, 50 tests – NanoVIP® |